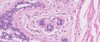

Histologi COPY COPY COPY Flashcards
(50 cards)
Hur är bröstet hos kvinnan uppbyggt?
- Uppbyggd av bröstkörtel i bindväv och fett samt omgivande stroma
- Börjar i mammilen och går in genom ductus lactiferi (större gång med flerskiktat skivepitel) i interlobulärt stroma som går genom mindre grenar in till terminal duct lubular unit (TDLU) som är mindre system (minsta delen i körtelträd) med kubiskt/cylindriskt epitel i terminala gångar omgivet av lucker bindväv (intralobulära stromat) och når till mjölkproduktion
- Myoepitelia celler är också del av TDLU, kontraherar
- Luminala celler i körtelstruktur, producera och transportera mjölk
- Alveoler differentieras från TDLU, enbart i aktiva bröstkörtlar

Vad visar bilden?

Inaktivt bröst
- Mkt stroma och lite körtlar, mkt fett (vita blobbar). Interlobulära stromat, kluster av körtlar (TDLU)
Vad visar bilden?
Inaktivt bröst
- TDLU (Terminal duct lobular units) – klustret - minsta delen i körtelträdet som tömmer sig i körtelgångar), intralobulär stroma, luminala celler som är kubiska och bildar gången. Myoepitelia i kanten av körtel (lite mörkare och plattare)-pilen
Vad visar bilden?

Aktivt bröst
- Mkt mer körtel i aktivt bröst, kaotiskt, stroma syns inte
Vad visar bilden?

Aktivt bröst
- Mkt mer körtel i aktivt bröst, kaotiskt, stroma syns inte
- I mitten i det vita kallas den terminala gången nu för acini, mjölkproteiner ses i mitten
Vad visar bilden?

Ovarie
- Längst ut i ovariet germinalepitel (mesovariet) (enkelt lager kubiskt epitel)
- Tunica albuginea – lager med bindväv (oregelbunden tät) näst ytterst
- Cortex med folliklar i kanten
- Medulla – välvaskulariserat i mitten
Vad visar bilden för typ av ägg?

- Primordialfolliken
Enkelt lager med platta follikelceller (granulosaceller

Vad är det för typ av ägg till vänster och längst ner på bilden?

-
Primärfollikel – tidig
- Kubiska follikelceller
- Zona pellucida (glykoproteiner) omger ägget

Vad är det för typ av ägg på bilden?

-
Primärfollikel – sen
- Follikelceller organiseras till flera lager granulosaceller
- Omkringliggande stromaceller bildar tekaceller (lite mer platta

Vad är det för typ av ägg i mitten på bilden?

-
Sekundärfollikel/antralfollikel
- 6-12 lager granulosaceller. Antrum börjar bildas
- Teka interna/externa

Vad är det för typ av ägg i mitten på bilden?

-
Graafi/mogen follikel
- Corona radiata (granulosa runt ägget), cumulus oophorus (spalt ut med granulosaceller), membrana granulosa (yttre lager)

Vad visar bilden?

Corpus luteum
- Omorganisering av den kollapsade follikeln och blir gigantiskt, nästan i hela ovariets kortex
- Granulosa-luteinceller centralt mot lumen
- Theca-luteinceller distalt om granulosaceller
Vad visar bilden?

Corpus albicans
Vad visar bilden?

Äggledare – Tuba uterina/salpinx
- Liknar GI-kanalen
- Veckad mukosa – endosalpinx med cylindriska, cilierade celler som puttar in ägget
- Cylindriska sekretoriska celler/pegceller (ej cilier)
- Lamina propria
- Muscularis – myosalpinx
- Inre cirkulärt, yttre longitudinellt
- Serosa – mesosalpinx
- Mesotel (ett lager platta celler med lite bindväv)
Vad visar bilden?

Del av äggledare/tuba uterina/salpinx
Äggledare – Tuba uterina/salpinx
- Liknar GI-kanalen
- Veckad mukosa – endosalpinx med cylindriska, cilierade celler som puttar in ägget
- Cylindriska sekretoriska celler/pegceller (ej cilier)
- Lamina propria

Vad visar bilden?

Uterus
-
Endometrium körtelstruktur som förändras med menstruationscykeln
- Cylindriskt epitel bildar körtlar
- Stratum basale (längst ner mot myometrium) (1/3)
- Stratum functionale – menstruation (2/3)
- Spirala artärer
- Menstruationsfas, proliferationsfas, sekretorisk fas
-
Myometrium
- Glatt muskulatur (tjockt lager)
- Serosa (perimetrium)
- Bilden visar att lagret är uppbyggt och redo för ägg, det lite mörkare med lite mer platta körtlar är stratum basale

Vad visar bilden?

Vagina
- Mucosa
- Stratifierat skivepitel med glykogen
- Lamina propria
- Muscularis – glatt muskulatur
- Adventitia
Hur är testikeln uppbyggd
- Tubuli semineferi (spermatogenes) -> straight tubuli (tubuli seminiferi recti) -> rete testis -> ductules efferentes -> epididymis (lång gång som är veckad) -> ductus/vas deferens
- Testikel vandrar ner från buken. Tar med sig lite av peritoneum (parietalt lager och visceralt lager) kallas för tunica vaginalis (hålrum emellan)
- Tunica albuigena och tunica vasculosa som går i testikel och avgränsar testikel

Vilka mognadssteg har spermien?
- Mognad spermie i tubuli semineferi
- Spermatogonium (basalt) -> spermatozyt (inte lika perfekt runda, större) -> spermatid (apikalt, mindre cell) -> spermatozoa (nästan färdig spemie med flagell mot lumen, fullt mogen i epididymis)

Vad visar bilden?

Testikel
- Tunica albuigena mellan Sädesbildande gångar
Vad visar bilden?

Testikel
- Tunica albuigena mellan Sädesbildande gångar
- Mörka runda cellkärnor komprimerade mest basalt – spermatogonium, ljusare större mer gryniga cellkärnor – spermatocyter, mindre mer apikalt – speramtider, innerst med flageller apikalt - spermatozoa
- Sertolliceller – stödjecell (med nukleol i cellkärnan)
- Leidigceller – testosteron (ej platta som fibroblaster)

Vad visar bilden?

Epididymis
- Pseudostratifierat cylinriskt epitel med stereocilia (apikal del av cellmembranet)
- Principalceller, basalceller, intraepiteliala lymfocyter
- Tunt lager glatt muskulatur
- Mognad och förvaring av spermier
- Kolla på epitel för att se skillnad på bitestikel och testikel

Vad visar bilden?

Epididymis
- Pseudostratifierat cylinriskt epitel med stereocilia (apikal del av cellmembranet)
- Principalceller, basalceller, intraepiteliala lymfocyter
- Tunt lager glatt muskulatur
- Mognad och förvaring av spermier
- Kolla på epitel för att se skillnad på bitestikel och testikel

Vad visar bilden?

Ductus deferens
- Veckad mukosa
- Pseudostratiferat cylindriskt epitel med stereocilia
- Lamina propria
- Tre lager av glatt muskulatur
- Inre longitudinellt
- Mellerst cirkulärt
- Yttre longitudinellt
- Adventitia (sitter fast med bindväv på andra organ)
- Många andra strukturer i adventitia






























